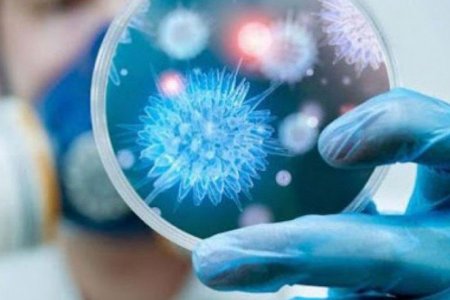
Коронавирусний халдвараас сэргийлэх аргууд

НЭМГ-аас мэдэгдэл гаргажээ
ДэлгэрэнгүйКоронавирусийн халдварт (COVID-19)-ын нөхцөл байдлын мэдээ /2020.03.21)
ДэлгэрэнгүйКоронавирусийн халдварт (COVID-19)-ын нөхцөл байдлын мэдээ /2020.03.20)
Дэлгэрэнгүй"Монголдоо хайртай" аяныг санаачлан эхлүүллээ
ДэлгэрэнгүйМонгол-Япон сургалтын эмнэлгийн санхүүжилт, техник, тоног төхөөрөмжийг цогцоор нь шийднэ
ДэлгэрэнгүйКоронавирусийн халдварт (COVID-19)-ын нөхцөл байдлын мэдээ /2020.03.19)
ДэлгэрэнгүйНийслэлийн 2-р амаржих газар АГААР ХАЛДВАРГҮЙЖҮҮЛЭГЧ төхөөрөмжтэй боллоо
ДэлгэрэнгүйХӨСҮТ-д эмчлүүлж буй франц иргэн Монголын ард түмэн болон эмнэлгийн ажилтнуудад хандан захидал бичжээ
ДэлгэрэнгүйИрэх даваа гарагаас 65 мянган угаар мэдрэгчийг дахин тараана
ДэлгэрэнгүйШ.Мөнгөншагай нарт холбогдох эрүүгийн хэргийн шүүх хурал хойшиллоо
ДэлгэрэнгүйЗарим гурилын үйлдвэрүүдийн үйлдвэрлэл, үнэ, нөөцийн байдалд хяналт тавьж ажиллалаа
ДэлгэрэнгүйКоронавирусний халдвараас сэргийлэх аргууд
ДэлгэрэнгүйОХУ-д суралцдаг монгол оюутнууд хоёр боомтоор л хил нэвтэрнэ
ДэлгэрэнгүйТусгаарлах байранд байгаа иргэдэд 14 хоногт нэг удаа 10:00-16:00 цагийн хооронд эргэлт оруулахаар боллоо
ДэлгэрэнгүйКоронавирусийн халдварт (COVID-19)-ын нөхцөл байдлын мэдээ /2020.03.19)
Дэлгэрэнгүй